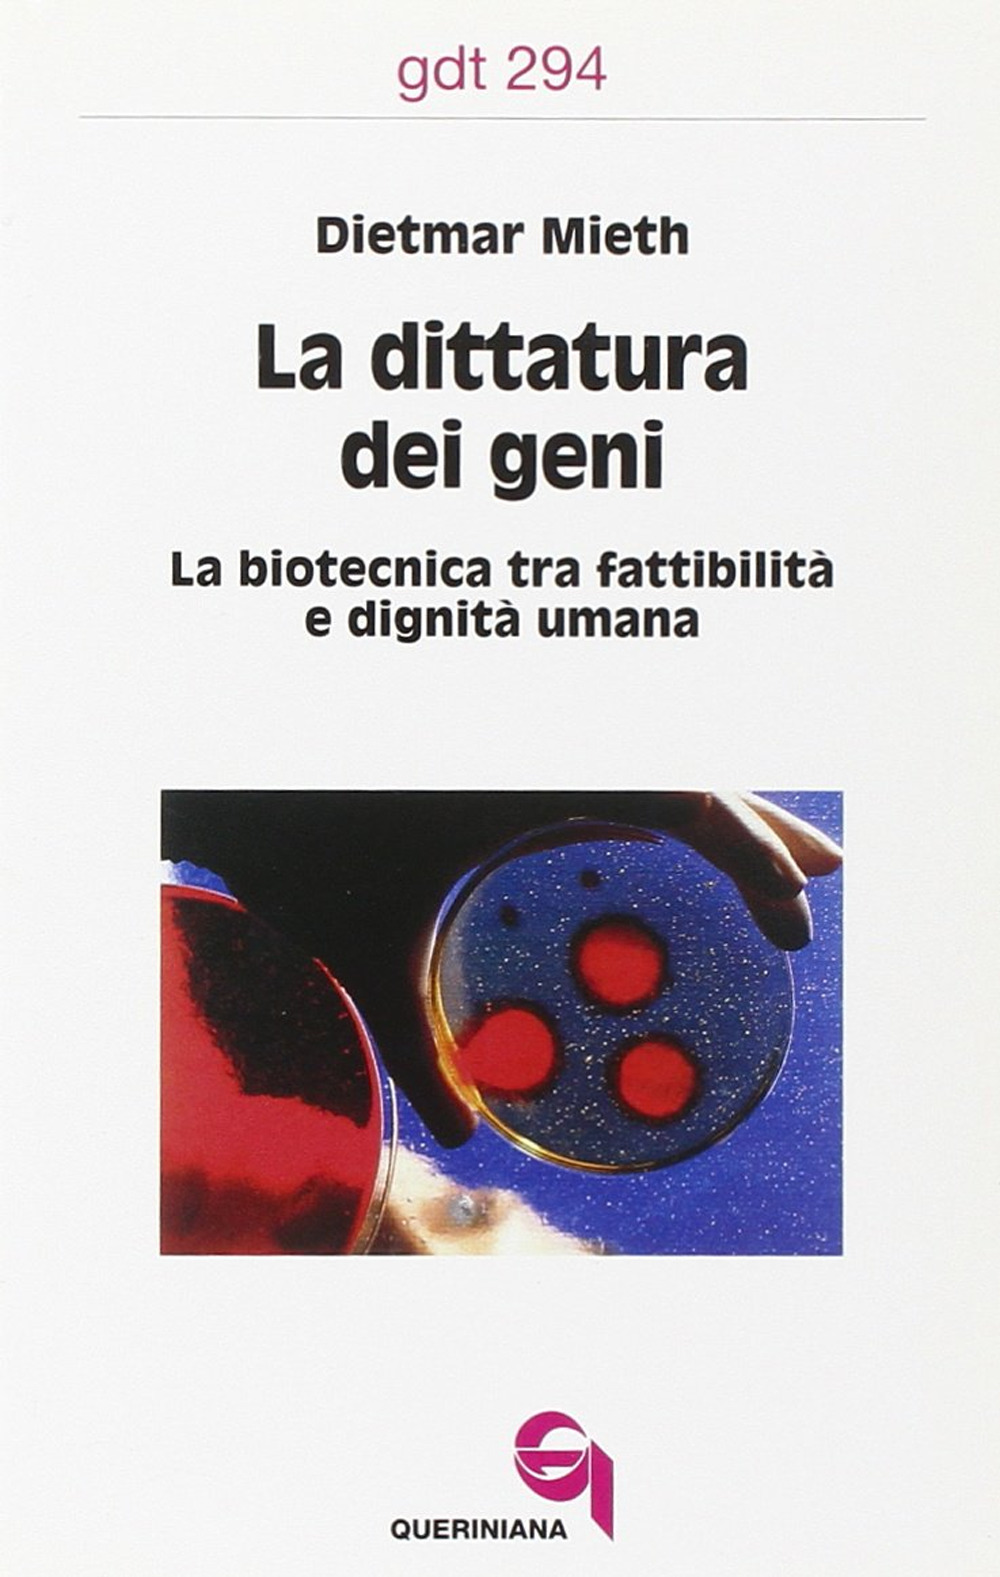
La dittatura dei geni. La biotecnica tra fattibilità e dignità umana

Autore
Dietmar Mieth
4 libri per questo autore.

Non disponibile
Società e antropologia
Scegliere la propria fine? La volontà e la dignità dei morenti
23,00 €
Non disponibile
Società e antropologia
Che cosa vogliamo potere? Etica nell'epoca della biotecnica
57,00 €
Non disponibile
Storia e società
La dittatura dei geni. La biotecnica tra fattibilità e dignità umana
16,00 €
Pagina 1 di 1
